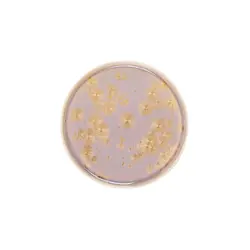
Тарелка с бортом, Royal Charm, Frost, 21 x 1.9 см
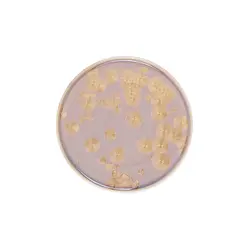
Тарелка с бортом, Royal Charm, Frost, 26 x 1.9 см
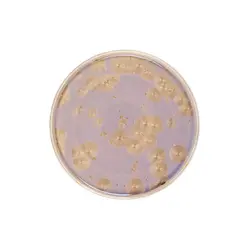
Тарелка с бортом, Royal Charm, Frost, 28 x 1.8 см

- 1
- 2
 Москва, Котельническая набережная 25с1.
Москва, Котельническая набережная 25с1.
+7 495 185 20 69
(с 10:00 до 19:00 пн-пт)
8 800 302 07 26
(Бесплатный звонок по России)
Royal Charm
Шоурум для профессионалов ресторанной индустрии
Напишите нам
Вы можете познакомиться с коллекциями посуды и предметов сервировки, обсудить задачи вашего проекта с персональным менеджером.
Шоурум работает только с юридическими лицами и по предварительной записи по телефону.
Напишите нам